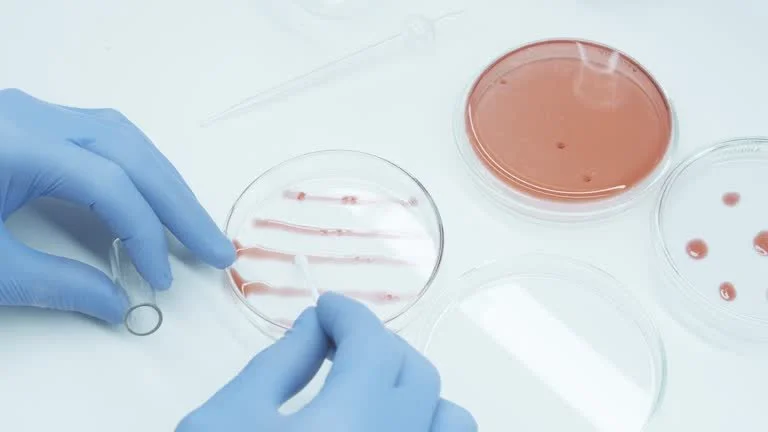

Our Services
-
Pharmacokinetics and Pharmacodynamics
-
Immunogenicity testing
-
Biomarker Analysis
-
Advanced Cell Engineering
-
Cell and Gene Therapy
-
Molecular Biology
-
Protein Characterization
-
Stability Studies
-
Botulinum Neurotoxin
-
Microbiology testing
-
Medical Device Testing
-
Consultations

Pharmacokinetics and Pharmacodynamics Testing
We provide specialized pharmacokinetic (PK) and pharmacodynamic (PD) testing services designed to deliver critical insights into the effectiveness and safety of therapeutic agents. Our expertise in pharmacokinetic bioanalysis encompasses a wide range of compounds, including peptides, fusion proteins, recombinant growth factors, cytokines, antibodies, and antibody conjugates.
Our services include:
BioTherapeutic Analysis: Assessing the efficacy and safety of biologics.
Dose-Concentration Testing: Evaluating the relationship between dosage and drug concentration in biological samples.
Biodistribution: Analyzing how drugs distribute throughout the body.
Tissue and Biopsy Assays: Conducting assays to evaluate drug effects in specific tissues and biopsies.

Immunogenicity Testing
At BioTether Sciences, we understand the critical role immunogenicity testing plays in the development of biotherapeutics. Our specialized services are designed to evaluate the immunogenic potential of your biologics, ensuring they meet regulatory standards and support clinical and non-clinical studies.
Our Immunogenicity Testing Services Include:
Evaluation of Immunogenicity of Biotherapeutics: We conduct comprehensive assessments to identify and quantify immune responses generated by your biotherapeutics. Our testing strategies help predict potential adverse reactions, enabling you to make informed decisions throughout the development process.
Bridging, Sandwich, and Other ELISA/ECLA Strategies: Our team employs advanced ligand binding assay methodologies, including bridging and sandwich ELISA, as well as electrochemiluminescent assays (ECLA). These techniques allow for the sensitive detection and quantification of anti-drug antibodies (ADAs), providing reliable data for your immunogenicity evaluations.
Compliance with Current FDA Guidance: We ensure that our immunogenicity testing adheres to the latest FDA guidelines. This commitment helps you align your studies with regulatory expectations, facilitating a smoother pathway to approval.
Support for Clinical and Non-Clinical Studies: Our services extend to both clinical and non-clinical settings. We support your research needs by providing data that helps assess the safety and efficacy of your biotherapeutics.
Anti-Drug Antibody Testing: We specialize in the detection and characterization of anti-drug antibodies (ADAs). Understanding the presence and implications of ADAs is crucial for evaluating the safety profile of your therapeutic candidates. Anti-drug antibodies may be measured using screening, confirmatory and titer tests.
Flow Cytometry: Our state-of-the-art flow cytometry capabilities enable detailed analysis of immune cell populations and their responses to biotherapeutics. This technique provides valuable insights into the immunological mechanisms at play, further supporting your drug development efforts.
At BioTether Sciences, we are dedicated to delivering high-quality immunogenicity testing services that meet your specific research needs. Our experienced team combines advanced technologies with a deep understanding of regulatory requirements, ensuring your biotherapeutics are rigorously evaluated for immunogenicity. Contact us today to learn how we can support your development programs.
Biomarker Analysis
Biomarkers are measurable indicators that reflect the biological state of an organism. They play a critical role in the diagnosis, prognosis, and treatment of various diseases, offering insights into disease mechanisms and potential therapeutic targets. At BioTether Sciences, we specialize in leveraging biomarkers to advance research and development in the biotechnology and pharmaceutical industries.
Novel Method Development: We understand that accurate and reliable biomarker detection requires innovative approaches. Our team excels in developing novel methodologies tailored to the specific needs of our clients. We utilize cutting-edge technologies and advanced analytical techniques to ensure precise measurement and validation of biomarkers in complex biological matrices.
Disease State Biomarkers: Identifying and characterizing disease state biomarkers is essential for understanding disease progression and response to treatment. Our expertise lies in discovering and validating biomarkers that can serve as indicators of disease presence, severity, and outcomes. We work closely with our clients to translate these findings into actionable insights, facilitating the development of targeted therapies and personalized medicine.
Mechanism of Action Studies: Understanding how a drug interacts with its target is crucial for effective therapeutic development. Our mechanism of action studies provide in-depth analysis of the biochemical pathways involved, allowing us to elucidate how potential therapeutics affect disease processes. By integrating biomarker analysis into these studies, we provide comprehensive insights that support drug development and regulatory submissions.
Biomarker Analysis: Our robust biomarker analysis services encompass a wide range of methodologies to support various research needs. From discovery to validation, we employ advanced techniques to ensure the reliability and relevance of biomarkers in clinical and preclinical settings. We help clients navigate the complexities of biomarker assessment, ensuring alignment with regulatory standards and scientific rigor. Assay performance characteristics include sensitivity, specificity, range, minimum required dilution, matrix effects, accuracy, precision, dilution linearity, and stability.
Clinical Trial Support: We offer specialized support for clinical trials, focusing on biomarker-driven approaches that enhance trial design and patient stratification. Our expertise in biomarker development and analysis enables us to assist clients in identifying suitable biomarkers for patient selection and monitoring therapeutic responses, ultimately improving trial outcomes. We have excellent systems for sample tracking, monitored ultra-low freezer storage, audit trail and data transfer.

Advanced Cell Engineering
We specialize in advanced cell engineering, leveraging cutting-edge technologies to deliver robust solutions for a range of research and clinical applications. Our expertise spans stable cell line generation, precise gene editing, viral and non-viral delivery systems, and comprehensive cell-based assays.
Stable Cell Line Generation: Our team develops custom cell lines that offer reliable expression of your gene of interest, optimized for both research and therapeutic purposes. This may include PiggyBac transposition or other vector based strategy to achieve stable integration.
AAV and Lentivirus Particle Packaging & Transduction: We provide efficient viral particle packaging and transduction services, delivering high-quality AAV and lentivirus particles tailored to your project needs.
Lipofection and Electroporation: We employ advanced techniques like lipofection and electroporation to introduce nucleic acids into a variety of cell types, ensuring high transfection efficiency.
CRISPR/Cas9 Line Generation and Characterization: Our CRISPR/Cas9 services enable precise gene modifications, with full characterization of edited lines to ensure target accuracy and reliability.
Primary Cell Culture Expertise: With years of experience in culturing primary cells, our lab supports complex projects that require the highest level of technical proficiency. We can isolate and grow human skin fibroblasts and hematopoietic stem cells.
Cell-Based Activity Assays: We offer a broad spectrum of assays to evaluate cell activity, from proliferation to signal transduction, ensuring you receive detailed insights into cell function.
Flow Cytometry Analysis: Our flow cytometry services deliver precise cell population data, helping you explore markers, cell cycle stages, and other essential parameters.
Proliferation, Cytotoxicity, and Cell Death Assays: We design assays to monitor cell growth, viability, and cytotoxic responses, providing critical data for drug development and research.
Signal Transduction and Reporter Assays: Measure pathway activation and cellular responses with our signal transduction and reporter assays, designed for accuracy and reproducibility.
Cell-Based Neutralizing Antibody Assays: We offer specialized assays to determine the neutralizing potency of antibodies, essential for vaccine and therapeutic antibody development.
Quality Control, Potency, and Lot Release Testing: We ensure your products meet stringent quality and potency standards through our thorough QC and lot release testing services.
Protein Characterization: Our protein characterization services include identity, purity, and potency testing, ensuring the quality of your biologics.
AAV Infectivity Potency Assays: We provide AAV infectivity assays to assess the biological activity of viral particles, ensuring consistent and reliable results for gene therapy applications.
Stability and Long-Term Storage: Preserve your critical materials with our stability and long-term storage solutions, designed to maintain functionality over extended periods.
Our comprehensive suite of advanced cell engineering services ensures that every aspect of your research and development is supported with precision, reliability, and expert knowledge. Reach out to learn how we can accelerate your next breakthrough.

Cell and Gene Therapy
Cell and gene therapies demand advanced tools for assessing nucleic acids, vectors, bioactivity, immunogenicity, and protein stability. With over 20 years of experience, our team brings expertise in the latest techniques to evaluate key quality attributes, clinical biomarkers, pharmacokinetics, and anti-drug antibodies, supporting both non-clinical and clinical studies as well as process validation.
To ensure rigorous monitoring of the manufacturing process, biochemical testing and bioassays are essential. Testing identity, purity, and potency often requires engineered reporter cell lines and specialized assays. We can use advanced platforms such as Flow Cytometry, ELISA/ECLA, qPCR, and customized bioassays to monitor the manufacturing process and evaluate critical reagents. BioTether Sciences can generate stable packaging and producer cell lines for production of AAV and Lenti vectors. Engineered cell lines and specialty assays are employed to test identity, purity, and potency, delivering reliable results tailored to your project needs. Capsid specific AAV serotypes may be measured or the potency (infectivity) in model cell types can be evaluated. We also provide immunogenicity screening services for total and neutralizing antibody assays. BioTether Sciences is also able to measure biodistribution of the therapeutic by QPCR and ligand binding assay in cells, tissues, and other matrices.
At BioTether Sciences, we are your experienced partner in ensuring the quality and success of your cell and gene therapy development. If you have a project in mind, we’d love to hear about it. Reach out to us anytime, and we'll be more than happy to discuss how we can best support your research.

Molecular Biology
At BioTether Sciences, we are dedicated to pushing the boundaries of research through our advanced molecular biology services. Our fully equipped laboratory provides a comprehensive suite of solutions to meet the diverse needs of researchers in genomics, proteomics, and cellular analysis.
Real-Time and Quantitative PCR: We specialize in Real-Time and Quantitative PCR (QPCR) techniques that allow for precise quantification of nucleic acids. These methods are essential for assessing gene expression levels, enabling researchers to draw meaningful conclusions from their data.
Gene Expression Analysis (RT-PCR/QPCR): Our Gene Expression Analysis services utilize both RT-PCR and QPCR methodologies to analyze and quantify RNA levels. This critical analysis helps unravel gene regulation mechanisms and their impacts on biological systems.
Single Nucleotide Polymorphism (SNP) Genotyping: SNP genotyping is vital for genetic association studies. We provide high-throughput genotyping services that accurately identify and characterize SNPs, facilitating your research in population genetics and disease association studies.
Sanger Sequencing: Our Sanger Sequencing services deliver high-quality DNA sequences with unmatched accuracy. This method is essential for validating PCR products, analyzing mutations, and conducting various genetic studies.
Copy Number Variation Analysis: Understanding Copy Number Variations (CNVs) is crucial for studying genetic disorders and cancer. We offer comprehensive CNV analysis to identify and characterize variations that may influence phenotype and disease susceptibility.
PCR for Gene Knock-out, Insertion, or Over-Expression: Our PCR services facilitate gene manipulation through knock-out, insertion, or over-expression techniques. This allows researchers to explore gene function and its role in cellular processes.
Cell and Tissue Homogenization, Protein and Nucleic Acid Isolation: We provide efficient protocols for homogenizing cells and tissues, alongside high-quality isolation of proteins and nucleic acids, ensuring optimal purity for downstream applications.
Cells to cDNA Library Preparation: Our expertise in cDNA library preparation enables researchers to create comprehensive libraries for gene expression analysis and functional studies.
Cellular Biomarker Analysis: We specialize in the identification and quantification of cellular biomarkers, aiding in disease diagnosis and therapeutic development.
Metabolic Markers and Activity Assays: Our metabolic markers and activity assays provide insights into cellular metabolism, helping researchers understand physiological and pathological states.
Tissue Biodistribution : We assess the biodistribution of compounds within tissues, which is essential for pharmacokinetic studies and drug development.
Biochemistry:
Protein Engineering: Our protein engineering services allow for the design and modification of proteins, enhancing their functionality and applicability in research and therapeutics.
Conjugations and Labeling, Positive Control Generation: We offer customized conjugation and labeling services, as well as the generation of positive controls to ensure assay reliability.
Custom Enzyme Activity Assay Development: Our team can develop tailored enzyme activity assays that meet the specific needs of your research.
Gel Electrophoresis, Western Blot, and Reporter Assays: We provide comprehensive analysis services, including gel electrophoresis, Western blotting, and various reporter assays to study protein expression and interactions.
Fast Protein Liquid Chromatography (FPLC): Our FPLC services ensure efficient and high-resolution purification of proteins, essential for downstream applications in research and development.

Protein Characterization and Biologics
We specialize in comprehensive protein characterization to ensure the quality and efficacy of your protein products, including probiotics, immune support formulations, adrenal health supplements, and bone health solutions. Our state-of-the-art methodologies enable us to assess various critical aspects of protein functionality and integrity, ensuring that your products meet the highest standards.
Enzyme Activity: We evaluate the enzyme activity of your protein products to determine their functionality. This analysis helps us understand how effectively the enzymes work under specific conditions, which is crucial for formulations aimed at promoting metabolic health and enhancing biological processes.
Antibody Binding and Characterization: Our antibody binding studies assess the affinity and specificity of antibodies to target antigens. This analysis is vital for ensuring the effectiveness of immune support products and therapeutic antibodies, providing insights into their potential applications in health and disease. Well characterized antibody and protein reagents is important for optimal assay development and testing.
Stability: We conduct stability testing to evaluate how well your protein products maintain their integrity over time. Our rigorous assessments under various conditions help identify factors that may affect protein stability, enabling you to optimize formulations for maximum shelf life and effectiveness.
Identity, Purity, and Potency: Our purity analysis determines the presence of contaminants and verifies the integrity of your protein products. By assessing purity levels, we ensure that your formulations are free from unwanted substances, which is essential for maintaining product quality and safety.
Quality Control Characterization: Using advanced techniques such as UV-Vis spectrophotometry and Bradford/BCA assays, we measure the identity and content of your protein products accurately. These assays provide reliable quantification, helping you ensure that your formulations contain the appropriate levels of active ingredients for optimal health benefits.

Stability Studies and Biospecimen Storage
At BioTether Sciences, we understand the importance of preserving biological samples for future research and development. Our services cover long-term storage, accelerated stability testing, biobanking, and cryo-storage, offering the latest in secure, temperature-controlled environments. With our trusted storage solutions, you can be confident that your samples will be maintained under optimal conditions, ensuring their readiness when you need them most.
What Customizable Services Do We Offer: At BioTether Sciences, we provide secure cryogenic storage, allowing you to preserve biological samples in an optimal environment to ensure viability.
How Do We Do It: To ensure successful preservation, we mix the cells with cryoprotective agents (CPAs), such as dimethyl sulfoxide, to prevent cell damage during freezing and thawing. We then proceed with other steps, including cooling, storage at cryogenic temperatures, thawing, and the removal of cryoprotectants.
What Do We Store: We store a variety of biological samples, including cell lines, primary human fibroblasts, isolated immune cells and stem cells. We also store lentiviral particles, adeno associated virus (AAV), proteins, enzymes, nucleic acids (such as DNA and RNA), and microorganisms like bacteria, yeast, and more.
What Equipment Do We Use: We use a range of specialized equipment, including: Ultra Low Freezer Controlled-rate freezers Liquid nitrogen cooled chambers.
Are We Prepared for Power Outages: While power outages at our facility are rare, we are fully prepared for any eventuality. We have backup generators to ensure continuous operation and the safety of stored samples.
How Long Is the Storage Period: We offer flexible agreements ranging from a few weeks to over a couple of years, giving you the freedom to choose a plan that aligns with your research timeline or storage needs.
How Do We Ensure Quality Assurance: All samples are registered in a central database for easy tracking and quality control.

Botulinum Neurotoxin
We offer comprehensive Botulinum neurotoxin characterization and testing services for Toxin A, Toxin B, and Toxin E, covering both the active pharmaceutical ingredient (API) and the finished drug product.
Methods Development: Development and validation of immunogenicity methods to assess anti-toxin antibodies in human serum. Cell Based Assays, Protein Characterization, Potency Assay.
Neurotoxin Stability testing: In this process we evaluate the stability of botulinum toxin products. This may include physical, temperature, chemical, and biological stability testing.
Potency and Antibodies: Botulinum toxin's potency is assessed through biological activity assays. These assays typically involve measuring the toxin's ability to inhibit neurotransmitter release (SNAP-25 proteolysis). Ligand Binding Assays and Cell Based Assays are used to measure total BoNT type A activity, protein levels and antibodies.

Microbiology Testing
Mycoplasma: Detecting mycoplasma contamination of cell lines is critical. Mycoplasma can impact the safety and quality of cell-derived biopharmaceutical products. We provide reliable mycoplasma testing using PCR or hybridization assays.
Endotoxin Testing
Pathogen Testing

Medical Device Testing
We excel in evaluating drug-device combination products, ensuring that both drug and device components are rigorously tested for optimal performance.

Consultations
At BioTether Sciences, we offer comprehensive consultation services designed to support your unique research and development needs. Our expert team brings extensive experience in biotechnology, bioanalysis, and advanced cell engineering, providing tailored guidance to help you navigate complex projects and challenges.
Whether you're a startup seeking strategic advice or an established organization looking to optimize your operations, our consultations cover a wide range of topics, including biomarker analysis, molecular biology techniques, and regulatory compliance. We prioritize understanding your specific objectives and challenges, enabling us to deliver actionable insights and strategies that drive innovation and efficiency.
Our comprehensive testing services equip clients with accurate and reliable data, empowering them to make informed decisions throughout the drug development process.
Partner with us to leverage our knowledge and expertise in the biotech sector, and ensure your projects are not only feasible but also aligned with the latest industry standards and practices. Contact us today to discuss how our consultation services can elevate your research and development initiatives.

Laboratory Space for Rent
If you are looking for lab space to rent, BT Innovation Labs is the first biotechnology incubator in the North Bay, strategically located amidst a vibrant biopharmaceutical landscape. Marin and Sonoma counties are home to industry leaders like BioMarin, Ultragenyx, and the Buck Institute for Research on Aging, with esteemed institutions such as Sonoma State and Dominican University nearby. Plus, the renowned UC Berkeley and UC San Francisco campuses are just a short drive away.
Our facility not only offers a safe and creative work environment surrounded by the natural beauty of the North Bay but also attracts entrepreneurs eager to innovate in biotechnology, ag-tech, food-tech, green energy, and medical devices. Founded and operated by biopharmaceutical industry experts, BT Innovation Labs provides a unique opportunity to join a thriving biotechnology ecosystem.
